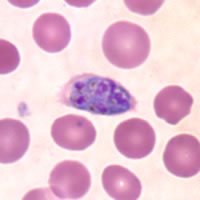

หน้าหลัก | สุขภาพดี | สุภาพสตรี | การแปลผลเลือด | โรคต่างๆ | ยารักษาโรค |วัคซีน | อาหารเพื่อสุขภาพ
การวินิจฉัยโรคมาลาเรีย พี.มาลาริอี
การวินิจฉัยโรคสามารถทำได้โดยการตรวจเลือดและย้อมวิธีพิเศษและส่องกล้อง
ส่วนระยะอื่นของเชื้อโรคเช่น Merozoites
ระยะRing form
การตรวจเลือดของผู้ป่วยที่เป็นมาลาเรียจะพบเซลล์เม็ดเลือดแดงมีขนาดปกติหรือใหญ่เล็กน้อย รอบตัวเซลล์ที่เหมือนขอบแหวนจะมีขนาดใหญ่ หัวแหวนจะมีขนาดใหญ่ ในเม็ดเลือดแดง 1 เซลล์อาจจะพบตัวเชื้อมาลาเรียได้หลายตัว
 |
รูปที่1เป็นเม็ดเลือดแดงปกติ ส่วนรูปที่ 2-5 เป็นการแสดงการเจริญเติบโตของตัวเชื้อมาลาเรีย

A |

B |
รูป A จะพบเซลล์เม็ดเลือดแดงที่มีการติดเชื้อมาลาเรียอยู่ 1 เซลล์ ส่วนรูป B จะพบเซลล์เม็ดเลือดแดงที่มีการติดเชื้อมาลาเรียและมีเม็ดสีSchüffner's dots
ตัวแก่ในระยวงแหวนเราเรียกระยะ Trophozoite ขอบวงแหวนจะมีขนาดใหญ่จะหนาและมีสีเข้มกว่าระยะแรก หัวแหวนมีขนาดใหญ่ และสามารถพบจุดSchüffner's dots เซลล์ตัวแก่จะมีเม็ดสีเหลืองในตัวเซลล์
 |
รูป 11-18 แสดงการเจริญเติบโตของเชื้อมาลาเรีย ระยะเซลล์เหล่านี้มักจะตรวจไม่พบในการตรวจเลือด
 |
 |
ในระยะนี้ไม่ค่อยพบในการตรวจเลือดเป็นเซลล์ตัวแก่ของ Trophozoite เรียก Scizont จะมีเม็ดสีเล็กๆ 6-14เม็ดเรียก merozoites เมื่อแก่เซลล์ก็จะแตกออก
 |
|
 |
 |
เป็นเซลล์ระยะเพศของมาลาเรีย เซลล์จะมีรูปร่างวงกลมหรือวงรีอยู่เต็มเซลล์เม็ดเลือดแดง
 |
 |
 |
ลักษณะสำคัญของ พี.มาลาอี
วงจรชีวิต >แหล่งระบาด >ลักษณะทางคลินิก >การวินิจฉัย >การรักษา >โรคแทรกซ้อน >การป้องกัน > มาลาเรียขึ้นสมอง
